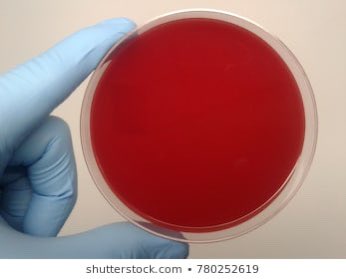
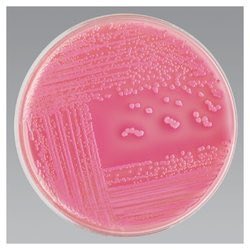

مساء الرّضـا متابعينا الأعِزّاء🤩❤️
مـاذا سيُقابلك فور دخولك أحد مختبرات الأحياء الدقيقة؟ كيف تُجمع العينات؟ وكيف يتم تحليلها؟
أجوبة كل هالاسئلة تلقونها في هذا الثريد:
الثريـد السـابق لمـن لم يقرأهُ بعد👇🏼✨:
#معلومة_اليومBW
مـاذا سيُقابلك فور دخولك أحد مختبرات الأحياء الدقيقة؟ كيف تُجمع العينات؟ وكيف يتم تحليلها؟
أجوبة كل هالاسئلة تلقونها في هذا الثريد:
الثريـد السـابق لمـن لم يقرأهُ بعد👇🏼✨:
#معلومة_اليومBW
و فيـهِ يتـم التعامل مع المراجعين بشكل مباشر من قبل فني التمريض أوأخصائي المختبر المتواجد.
🔻مـاهـي العيـنات التي تُجـمع في قسـم الإستقبـال؟
- عينات الـدم
- عينات البـول
- عينات البـراز
- عينات السائل المنـوي
- عينات سوائل الجسم المختلفـة
- عينات المسحات بكُل أنواعـها.
- عينات الـدم
- عينات البـول
- عينات البـراز
- عينات السائل المنـوي
- عينات سوائل الجسم المختلفـة
- عينات المسحات بكُل أنواعـها.
🔴 فالّلون الأحمـر؛ يُشير إلى وجود عينة موجبة مما يتطلب من الأخصائيين إبلاغ الطبيب بشكل فوري.
🔵أمـا الّلون الأزرق؛ فـبدوره يُشير إلى وجود عينات سالبة.
🔵أمـا الّلون الأزرق؛ فـبدوره يُشير إلى وجود عينات سالبة.
🔸من الجدير بالذكر، أن التنبيه قد يستغرق فتره من يوم إلى سبعة أيام في حال وجود ميكروبات في العينة أما في حال عدم حدوث التنبيه بعد هذه المدة فيتم التخلص من العينة وإبلاغ الطبيب بخلو العينة من أي ميكروبات.
لتحليل الـدم اختبارين للتـأكد من خلو العينات من الميكروبـات؛
🔹الإختبـار الأول: عزل البكتيريا مـن العيـنة/
🔻يُستخـدم هذا الإختبار لعـزل البكتيريـا من العينة في البيئات المخصصة لها حتى نتمكن من تحديد نوعها.
🔹الإختبـار الأول: عزل البكتيريا مـن العيـنة/
🔻يُستخـدم هذا الإختبار لعـزل البكتيريـا من العينة في البيئات المخصصة لها حتى نتمكن من تحديد نوعها.
🔸طريقة اجراءه:
نأخذ (1) مل من العينـة بإستخدام ابرة معقمة، بعدها يتم وضع قطرة في كل طبق من الأطبـاق والتخطيط الرباعي باستخدام الابرة.
نأخذ (1) مل من العينـة بإستخدام ابرة معقمة، بعدها يتم وضع قطرة في كل طبق من الأطبـاق والتخطيط الرباعي باستخدام الابرة.
❗️ملاحظـة: في العينات اللاهوائيـة يتـم اضافة طبق آخر من Blood Agar، وذلك حتـى يتم وضعه منفصلًا في حضـان آخر خالـي تمامـًا من الأكسجين.
🔸الإختبار الثالث: تحديـد نوع البكتيريا وحساسيته للمضادات/
يتم في هذا القسم استخدام أجهزة Vitek أيضا بإتباع الطريقة نفسها لعينات الدم.
#علم_الأحياء
#biology_world
يتم في هذا القسم استخدام أجهزة Vitek أيضا بإتباع الطريقة نفسها لعينات الدم.
#علم_الأحياء
#biology_world
جاري تحميل الاقتراحات...